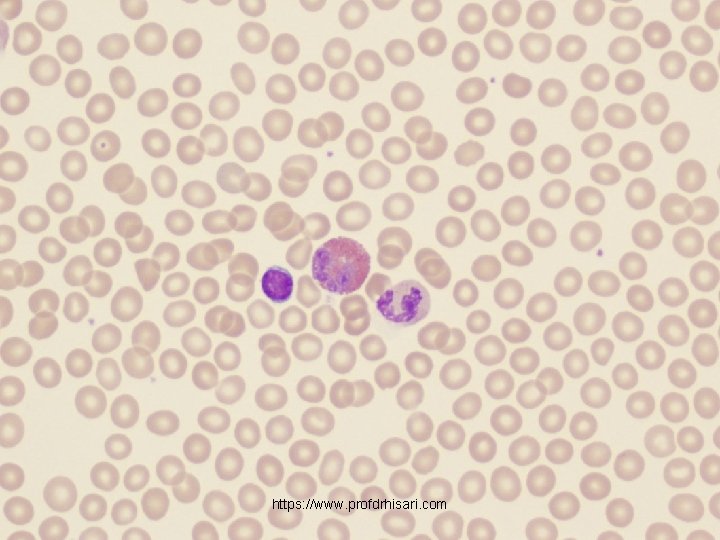
https: //www. profdrhisari. com
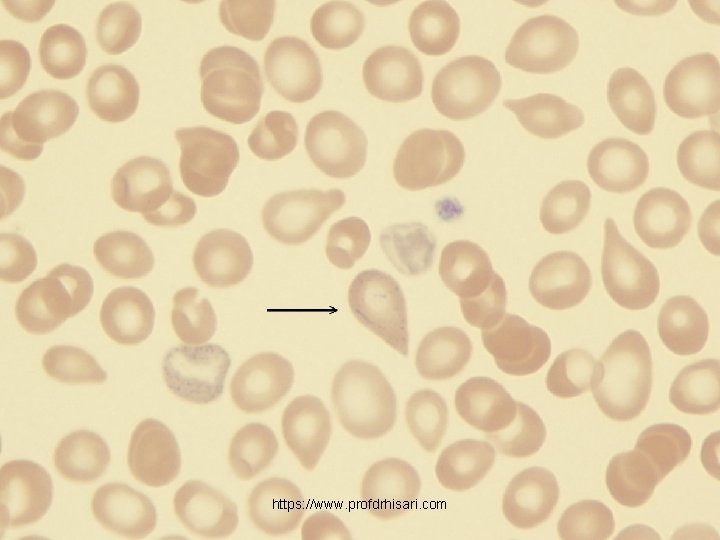
https: //www. profdrhisari. com
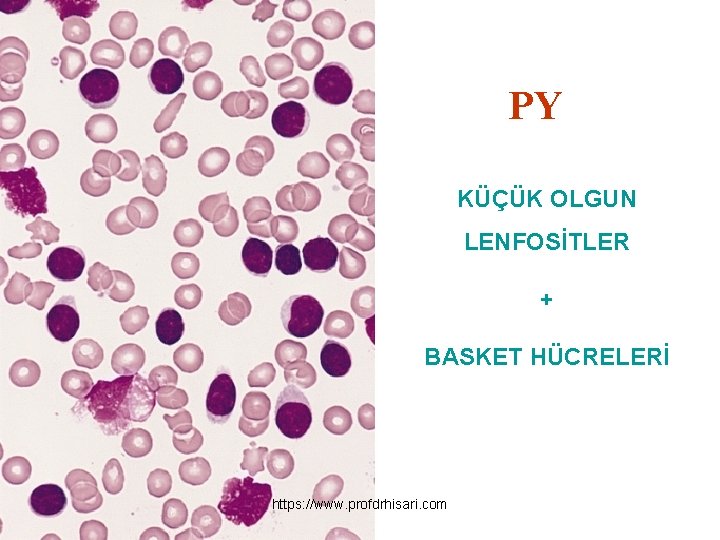
PY KÜÇÜK OLGUN LENFOSİTLER + BASKET HÜCRELERİ https: //www. profdrhisari. com

LKOSTOZLU HASTAYA YAKLAIM https www profdrhisari com https

- Slides: 94
LÖKOSİTOZLU HASTAYA YAKLAŞIM https: //www. profdrhisari. com
https: //www. profdrhisari. com
https: //www. profdrhisari. com
https: //www. profdrhisari. com
LÖKOSİTLER https: //www. profdrhisari. com
Normal Lökosit Dağılımı Normal lökosit sayısı 4 000 -10 000/mm 3 Hücre tipi Yüzde Mutlak sayı (hücre/mm 3) Nötrofil parçalı 50 -70 1500 -7000 Nötrofil çomak 2 -6 ≤ 1000 Lenfosit 20 -40 600 -4000 Monosit 2 -9 100 -900 Eozinofil parçalı 2 -4 ≤ 700 https: //www. profdrhisari. com Bazofil parçalı ≤ 100
Lökositoz LÖKOSİTOZ >10. 000 -11. 000/mm 3 MUTLAK LÖKOSİTOZ Sayısal artış RELATİF LÖKOSİTOZ NÖTROFİLİ LENFOSİTOZ MONOSİTOZ EOZİNOFİLİ BAZOFİLİ https: //www. profdrhisari. com % artışı
NÖTROFİL GELİŞİMİ https: //www. profdrhisari. com
NÖTROFİL 9 gün 36 saat https: //www. profdrhisari. com 1 -4 gün
KEMİK İLİĞİ https: //www. profdrhisari. com
https: //www. profdrhisari. com
NÖTROFİLİ • Mutlak nötrofil sayısının ~7. 000/u. L'nin üzerinde nötrofil olması • Nötrofilik Lökositoz: Mutlak nötrofil sayısının artışı ile birlikte Lökosit sayısının 11. 000/u. L üzerinde olmasıdır. • Çoğu olguda neden barizdir https: //www. profdrhisari. com
Olgu Sunumu-1 • 40 y, bayan hasta • Sağlık ocağında tarama amaçlı yapılan hemogramda; – WBC: 14. 000μ/L – Neu (PNL): 12. 600 μ/L – Hb: 14 g/d. L – PLT: 540. 000 μ/L ÖYKÜDE NE SORGULAYALIM? FM’de nelere dikkat edelim? Ek tetkik isteyelim mi? https: //www. profdrhisari. com
NÖTROFİLİ YALANCI NÖTROFİLİ PRİMER • Myeloproliferatif hastalıklar (KML , PV, ET, MF) • Konjenital nedenler • Siklik nötrofili • Kronik idyopatik nötrofili SEKONDER İnfeksiyon ve inflamasyon hst. Stres, egzersiz, depresyon Travma Cerrahi Gebelik Myokard infarktusu Sigara İlaclar (Lityum, steroid) Solid Tumorler, MM Hemoliz Endokrin hastalıklar Aspleni ve hipospleni https: //www. profdrhisari. com Böcek, yılan, akrep sokması
Olgu Sunumu-1 • Hastadan detaylı öykü alınmadan ve FM yapılmadan SAM 2 X 1 tb başlanarak gönderilmiş. • 3 ay sonra tam teşekküllü bir hastaneye ateş, öksürük, balgam, halsizlik yakınmaları ile başvurmuş. • FM’de her iki AC bazalde raller, taşikardi https: //www. profdrhisari. com
Olgu Sunumu-1 • Yapılan tetkiklerde; – WBC: 35. 000μ/L – Neu (PNL): 32. 600 μ/L – Hb: 12. 1 g/d. L – PLT: 640. 000 μ/L Sed: 58 mm/saat CRP: 6. 5 (<0. 5) https: //www. profdrhisari. com
Olgu Sunumu-1 • Hastaya yatırılarak geniş spektrumlu IV antibiyotik tedavisi başlanmış. • 48. saatte ateşi düşen hastanın IV antibiyotik tedavisi 7 güne tamamlanarak oral antibiyotikle taburcu edilmiş. YATTIĞI SÜRE İÇİNDE VE TABURCU EDİLİRKEN KAN SAYIMI KONTROLÜ YAPILMAMIŞ! https: //www. profdrhisari. com
NÖTROFİLİDE İPUÇLARI • Çoğunlukla sekonder nedenlere bağlıdır. • İnflamasyonla ilişkili sekonder nedenlerde akut faz reaktanları (Sed, CRP) genellikle yüksektir. • Primer nedenlerden en sık görülenler MPH – – – Genellikle asemptomatik Öykü uzun solukludur Nötrofili süresi uzundur. CRP, Sed düşüktür En çarpıcı FM bulgusu splenomegalidir • Özellikle KML ve PMF’de çok büyük olabilir. https: //www. profdrhisari. com
NÖTROFİLİDE İPUÇLARI • Sekonder nedenlerde genellikle total lökosit sayısı 25. 000/μL’yi geçmez. • >30. 000/μL “Lökomoid Reaksiyon” • KML’de genellikle 25. 000 -500. 000 /Μl • Tam kan sayımında nötrofili dışındaki patolojilerin varlığı https: //www. profdrhisari. com
Lökomoid Reaksiyon • Lökomoid reaksiyon, lökositlerin benign sekonder sebeplere bağlı olarak lösemiye benzer şekilde artmasıdır. • Lökomoid reaksiyon için alt lökosit sınırı > 30. 000/u. L 'dir. • Hakim olan hücre tipi genellikle granülositlerdir. • Granülositik lökomoid reaksiyonlar genellikle erişkinlerde görülür. • Lenfositik lökomoid reaksiyonlar ise çocuklarda daha sıktır. https: //www. profdrhisari. com
Lökomoid Reaksiyon nedenleri • İnfeksiyonlar: pnomoni, sepsis, tbc, meningokoksik menenjit, EMN, Boğmaca, hepatit, CMV, kabakulak • İntoksikasyon • Yanık • Eklampsi • Kemik iliği metastazı yapan tümörler • Alkolik hepatit • Diabetik ketoasidoz • Şiddetli kanama • Hemolitik anemi • KT, infeksiyon sonrası gelişen nötropeni recovery döneminde • RA gibi otoimmün veya vaskülitik hastalıkların seyrinde • İlaçlar https: //www. profdrhisari. com
Lökomoid Reaksiyon • PY’da bazofili ve eozinofili genellikle olağan bir bulgu değildir fakat altta yatan hastalığa bağlı olarak görülebilir. • Genç ve çomaklar artmış olabilir ama immatür formlar yoktur. • Trombosit sayısında hafif artış görülebilir fakat genellikle 600. 000/mm 3 geçmez. • Nötrofili altta yatan hastalığın tedavisi ile düzelir. • Kronik myeloproliferatif hastalıklardan ayrılmasında splenomegali, Ph kromozomu, lökosit alkalan fosfataz boyası ve kemik iliği incelemesi yararlıdır. https: //www. profdrhisari. com
https: //www. profdrhisari. com
Olgu Sunumu-1 • Hasta taburcu olduktan 3 ay sonra yavaş gelişen, fakat son zamanlarda artan halsizlik, terleme, sol üst kadran ağrısı ile Gastroenteroloji’ye başvurmuş. • FM’de konjonktivalarda hafif solukluk ile birlikte dalak kot altında 4 cm palpe edilmiş. https: //www. profdrhisari. com
Olgu Sunumu-1 • Yapılan tetkiklerde; – WBC: 44. 000μ/L – Neu (PNL): 40. 600 μ/L – Monosit: 3800 μ/L – Hb: 10. 4 g/d. L – PLT: 720. 000 μ/L Sed: 10 mm/saat CRP: 0. 3 (<0. 5) ÖYKÜDE NE SORGULAYALIM? FM’de nelere dikkat edelim? Ek tetkik isteyelim mi? https: //www. profdrhisari. com
Myeloproliferatif Hastalıklar • Kronik Myeloid Lösemi • Polisitemia Vera • Esansiyel Trombositoz • Myelofibrozis https: //www. profdrhisari. com
Myeloproliferatif Hastalıklar • Hematopoietik kök hücrenin neoplastik, klonal, ilerleyici ve kronik hastalıklarıdır. • Genellikle ileri yaşlarda görülür (50 -75) • Genelde asemptomatikdirler • Splenomegali en önemli FM bulgusudur. • Nötrofilik lökositoz (immatür formlarla birlikte) en önemli laboratuar bulgusudur, fakat diğer serilerde de artış olabilir. • Sed ve CRP genellikle düşüktür. https: //www. profdrhisari. com
https: //www. profdrhisari. com
Kronik Myeloid Lösemi https: //www. profdrhisari. com
Kronik Myeloid Lösemi https: //www. profdrhisari. com
Kronik Myeloid Lösemi • Bulguların ortaya çıkışı ile tanı arasındaki süre yaklaşık 1 yıldır (Sessiz Dönem) • Klinik Dönem 3 fazlı bir seyir gösterir Kronik stabil faz Akselere faz Blastik faz • Kronik stabil faz süresi 3 -4, 5 yıldır. https: //www. profdrhisari. com
KML-Semptomlar • Sol üst kadranda dolgunluk hissi • Halsizlik, uykuya meyil • Karın ağrısı • Kanama diyatezi • Görme bozukluğu • Terleme ve zayıflama https: //www. profdrhisari. com
KML-Klinik Bulgular • Palpabl splenomegali (% 75) • Hepatomegali • Ekimoz • Hematom • Tromboz • Granulositik sarkom https: //www. profdrhisari. com
KML-Laboratuvar • Periferik yaymada Kemik iligi myeloid seri hücreleri artışı ( Kemik iliğine benzer PY görünümü) • Lökositoz (25 -500 x 109/L) en tipik bulgusudur. • Lökosit alkalen fosfataz (LAP) skoru sıfıra yakın • Bazofili & Eozinofili • Serum vit B 12 düzeyi ve vit B 12 bağlayıcı protein artmıştır. • Kemik İliği hipersellüler • t (9; 22): Philedelphia kromozomu https: //www. profdrhisari. com
https: //www. profdrhisari. com Normal kemik iliği
https: //www. profdrhisari. com
Polisitemi Vera • Her üç seri de artar ancak eritrositer seri artışı ön plandadır. • Genellikle 50 yaş civarında görülür ve erkeklerde daha sıktır. • Çogu zaman polisitemi varlığı başka bir nedenle yapılan tam kan tetkiki sırasında ortaya çıkar. https: //www. profdrhisari. com
PV-Semptomlar % Baş Ağrısı 48 Güçsüzlük 47 Kaşıntı 43 Baş Dönmesi 43 Terleme 33 Görme Bozuklukları 31 Kilo Kaybı 29 Parestezi 29 Dispne 26 Eklem Semptomları 26 Epigastrik Rahatsızlık https: //www. profdrhisari. com 24
PV-Klinik Bulgular Bulgu % Splenomegali 70 Plethora (Cilt) 67 Plethora (Konjuktival) 59 Göz bulguları 46 Hepatomegali 40 Sistolik Kan basıncı >140 mm. Hg 72 Diasistolik Kan basıncı >90 mm. Hg 32 https: //www. profdrhisari. com
PV-Klinik Bulgular • Eritromelalji • Aspirine cevap veren bacak ağrısı ve kemik hassasiyeti • Arteryel ve venöz tromboemboliler, • Artrit • Kanama: Epistaksis, GIS kanaması • Periferik damar hastalığı https: //www. profdrhisari. com
PV-Laboratuvar Tam kan sayımı: • Htk: • Hb= 18 -24 g/d. L arasında değişir • Kadın>%48 Erkek>%52 üst sınırlardır. • Lökosit: • Olguların yaklaşık yarısında artar • Nadiren 50. 000/mm³ olabilir. • Eozionofili ve bazofili görülebilir • Trombosit: • Trombositoz olguların %80’inde görülür • Genellikle 500. 000/mm↑, PDW ↑ https: //www. profdrhisari. com
PV-Laboratuvar Nötrofil alkalen fosfataz: • Hastaların %70’inde yükselmiştir Ferritin: • Ferritin düzeyi sekonder konjenital ve akkiz eritrositozlara göre düşük olma eğilimindedir. Vit B 12: • Artmış nötrofil kitlesinden salgılanan transkobalamin nedeniyle yüksek olabilir. Folat düzeyi: • Genellikle azalmıştır. https: //www. profdrhisari. com
Esansiyel Trombositoz 1) İki farklı zamanda yapılan sayımda plateletlerin 600. 000’ in üzerinde (sıklıkla bir milyonun üzerinde) 2) Hb, HTC ve kırmızı hücre değerleri normal. 3) Lökositoz > 10. 000 ( % 25 -40) 4) Reaktif trombositoz nedenlerini dışlamak gerekir. https: //www. profdrhisari. com
Reaktif Trombositoz • Maligniteler • Kronik İnflamatuvar hastalıklar (RA, Üls. Kolit, Crohn hst. . . ) • İnfeksiyonlar • Akut kanamalardan sonra • Egzersiz sonrası • Demir eksikliği ****Reaktif trombositozda PLT sayısı 1 milyonu geçmesi pek beklenmez https: //www. profdrhisari. com
ET-Klinik • Hastaların % 30’u semptomsuzdur. • Hastaların % 35’inde gastrointestinal kanamalar görülebilir. • Hastaların % 25 -40’ında genellikle arteriel sistemde embolileri sonucu serebro-vasküler olaylar (stroke, TIA, ve nadiren epilepsi ) görülür. https: //www. profdrhisari. com
ET-Klinik • % 35 -40’ında paresteziler • Eritromelalji • Yaklaşık ¼’ünde vasküler tipte başağrıları • % 70 -85 inde splenomegali • % 10 -15’inde hepatomegali görülür. https: //www. profdrhisari. com
Primer Myelofibroz a) Splenomegali (masif tarzda). b) Anemi (hemoliz veya yapımda azalmaya bağlı). c) Erken dönemde lökositoz ve trombositoz (% 60) ) d) Periferik kanda lökoeritroblastoz e) Periferik kanda gözyaşı hücreleri f) Kİ de retiküler bir fibrozis mevcut olması g) İskelet filmlerinde osteosklerozis https: //www. profdrhisari. com
https: //www. profdrhisari. com
https: //www. profdrhisari. com
https: //www. profdrhisari. com
https: //www. profdrhisari. com
Olgu Sunumu-1 • Periferik yaymada PNL’ler ile birlikte, myeloid progenitör hücreler (myeloblast, promyelosit, metamyelosit) izlendi. • LAP skoru düşük idi. • Kİ asp hipersellüler idi. • t (9; 22) pozitif saptandı. https: //www. profdrhisari. com
Lenfositler • Kanda nötrofillerden sonra en çok bulunan beyaz küre hücreleri • Lökositlerin en küçüğü • Bağışıklık mekanizmasından sorumlu hücreler • T ve B olmak üzere iki alt tipi var. https: //www. profdrhisari. com
Lenfositoz • Mutlak lenfosit sayısının ~4. 000/u. L'nin üzerinde olması • Lenfositik Lökositoz: Mutlak lenfosit sayısının artışı ile birlikte lökosit sayısının 11. 000/u. L üzerinde olmasıdır. https: //www. profdrhisari. com
Olgu sunumu-2 • 60 y, erkek hasta • İnguinal fıtık nedeniyle opere olmak için yapılan operasyon öncesi tetkiklerde lökositoz saptanmış. • FM’de – Aksiller, inguinal ve servikal bölgede en büyüğü 3. 0 x 1. 5 cm lenf nodları https: //www. profdrhisari. com
Olgu sunumu-2 • Laboratuvar bulguları ise; – lökosit: 45. 500/mm 3, – Lökosit formülünde lenfosit artısı (%65) – Hb: 13. 9 g/d. L – PLT: 155. 000/mm 3 – Eritrosit sedimentasyon hızı: 65 mm/saat, – CRP: 2. 50 (<0. 5) mg/d. L. https: //www. profdrhisari. com
Lenfositoz PRİMER • Lenfositlerdeki intrensek defekte bağlı mutlak lenfositoz • Lenfoid maligniteler • KLL • Kİ tutulumu ile giden lenfomalar • ALL SEKONDER • EMN • Mononükleoz sendromları • CMV, HIV, Adenovirus, Toxo, HSV • Akut İnfeksiyöz lenfositoz • Coxsackie virus, enterovirus • Postsplenektomi lenfositozu • Sigara içimi • Otoimmün hastalıklar https: //www. profdrhisari. com
Lenfositoz • Genellikle sekonder nedenlere bağlıdır. • İnfeksiyonlar özellikle viral nedenler ilk sırayı alır. • Akut başlangıç, Sed, CRP değerlerinde sınırda yükseklik, normal hemoglobin ve trombosit düzeyleri daha çok viral infeksiyon lehine • Yaş ilerledikçe maligniteyi daha ön planda düşünelim. https: //www. profdrhisari. com
Lenfositoz • Uzun seyirli öykü, Sed, CRP değerlerinde yükseklik, hemoglobin ve trombosit düzeylerinde azalma kronik lenfoproliferatif hastalıkları (KLL, lenfoma) • Akut başlangıç, Sed, CRP değerlerinde belirgin yükseklik, hemoglobin ve trombosit düzeylerinde ani düşüş akut lösemileri https: //www. profdrhisari. com
Olgu sunumu-2 • 60 y, erkek hasta • Laboratuvar bulguları ise; • İnguinal fıtık nedeniyle – lökosit: 45. 500/mm 3, opere olmak için yapılan – Lökosit formülünde operasyon öncesi tetkiklerde lenfosit artısı (%65) lökositoz saptanmış. – Hb: 13. 9 g/d. L – PLT: 234. 000/mm 3 • FM’de – Eritrosit sedimentasyon – Aksiller, inguinal ve hızı: 65 mm/saat, servikal bölgede en – CRP: 2. 50 (<0. 5) mg/d. L. büyüğü 3. 0 x 1. 5 cm lenf nodları https: //www. profdrhisari. com
Kronik Lenfositik Lösemi • B kökenli lenfositlerin aşırı çoğalması, LAP ve HSM ile karakterize yavaş seyirli kronik lenfoproliferatif bir hastalıktır. • Kronik lenfoid lösemiler içinde en sık görülenidir • Erişkinde en sık görülen lösemi türüdür https: //www. profdrhisari. com
Kronik Lenfositik Lösemi • İleri yaşta, 60 -80 yaşlarında pik yapar (30 yaşın altında nadir). • Erkek / Kadın = 2/1 https: //www. profdrhisari. com
EVRELEME EVRE 0 Lenfositoz (15. 000/mm³) EVRE 1 Lenfositoz + LAP EVRE 2 Lenfositoz + SM + HM EVRE 3 Lenfositoz + Anemi ( Hb< 10 gr/dl) EVRE 4 Lenfositoz + Trombositopeni (< 100. 000/mm³) https: //www. profdrhisari. com
Kronik Lenfositik Lösemi • Tanı anında hastalar genellikle asemptomatikdir. • Vakaların çoğu ( özellikle Evre 0 ) rutin kan testlerinde lenfositoz görülmesi ile tanınır veya başka bir tıbbi sorun nedeniyle yapılan FM’de LAP veya HSM saptanması ile farkedilir. • En sık FM bulgu simetrik, superfisiyal LAP’ tır. • İleri evrelerde hepatomegali ve splenomegali sıktır, • Tonsiller büyüme olabilir. https: //www. profdrhisari. com
PY KÜÇÜK OLGUN LENFOSİTLER + BASKET HÜCRELERİ https: //www. profdrhisari. com
Olgu sunumu-3 • 16 y, erkek hasta • Yüksek ates nedeniyle İnfeksiyon hastalıkları polikliniğine başvurmuş • Aksiller, servikal, oksipital, postaurikal bölgede lenfadenopatiler • Dalak kot altında 4 cm palpabl • Sırtta yoğunlasan makülopapüler ekzantematöz https: //www. profdrhisari. com döküntüler
Olgu sunumu-3 • Laboratuvar bulguları – WBC: 17. 500/mm 3, – Lenfosit: 13. 100/mm 3 – Monosit: 1. 800/mm 3 – Hb: 14. 1 g/d. L, – Sed: 28 mm/saat, – CRP: 0. 8 (>0. 5) mg/d. L – AST: 68 – ALT: 145 https: //www. profdrhisari. com
Olgu sunumu-3 https: //www. profdrhisari. com
İNFEKSİYÖZ MONONÜKLEOZ • İM çocuk ve genç erişkinlerde sık • Uzamış ateş, farenjit, boğaz ağrısı, LAP • Etken %80 EBV’dir • İnkübasyonsüresi 30 -50 gün (çocuk 10 -14 gün) https: //www. profdrhisari. com
İM-Epidemiyoloji • EBV, tükrük ve boğaz salgısıyla çıkarılır. • Yakın temasla, kanla veya kontamine eşyalarla kişiden kişiye bulaşmaktadır. • Yakın temasla sık bulaştığı için öpüşme hastalığı “Öpücük Hastalığı" olarak da bilinir. https: //www. profdrhisari. com
İM-Klinik • 3 -5 gün boğaz ağrısı (7 -10 gün) miyalji, retrobulber ağrı, ateş (10 -14 gün), öksürük, üşüme, titreme, terleme gibi prodrom belirtiler • Tonsiller hipertrofik farenks hiperemik ve genellikle eksudatiftir. • Olguların %80 -90‘ında posterior servikal LAP vardır. Ağrısız, hafifsert ve mobildirler. • %10 -15'inde hepatosplenomegali vardır. • Gövde ve ekstremitelerde makülopapüler, peteşi, ürtikeryal veya eritema multiforme benzeri döküntüler (Ampisilin kullananlarda) https: //www. profdrhisari. com
İM-Laboratuvar • Lökopeni • AST, ALT, LDH ve ALP 2 -3 kat artabilir. • Hastalığın 2. veya 3. haftasında lenfositoz • Mononükleer hücreler %60 -70 oranındadır. – %30'u. Downey cell • Serolojik testler • EBV izolasyonu • EBV-DNA https: //www. profdrhisari. com
DOWNEY HÜCRELERİ https: //www. profdrhisari. com
Eozinofil • Lökositlerin %2'sini oluşturur • Dolaşımdaki nötrofillerin %1 -6’sını oluştururlar https: //www. profdrhisari. com
Eozinofili • Mutlak eozinofil sayısının ~700/u. L'nin üzerinde olması • Eozinofilik Lökositoz: Mutlak eozinofil sayısının artışı ile birlikte lökosit sayısının 11. 000/u. L üzerinde olmasıdır. https: //www. profdrhisari. com
Eozinofili Nedenleri • Alerjik hastalıklar – Allerjik rinit – Astma • İlaçlar • İnfeksiyöz hastalıklar • Hematolojik ve neoplastik hastalıklar – – Lenfoma* Hipereozinofilik sendrom MPH* MF https: //www. profdrhisari. com
Eozinofili Nedenleri • • Kollajen doku hst Vaskülitler Adrenal yetmezlik İmmün etmezlikler https: //www. profdrhisari. com
Monosit • Monositler en büyük beyaz kürelerdir. • Düzensiz gri-mavi stoplazmalı ve lobüle çekirdekli hücrelerdir. • Monositlerin ortalama ömürleri 70 saattir. • Monositler kandan dokulara geçtiklerinde isimleri doku makrofajlarıdır ve hiç bir zaman geri kana dönmezler. https: //www. profdrhisari. com
Monositoz • Mutlak monosit sayısının ~1. 000/u. L'nin üzerinde olması • Monositik Lökositoz: Mutlak monosit sayısının artışı ile birlikte lökosit sayısının 11. 000/u. L üzerinde olmasıdır. https: //www. profdrhisari. com
Olgu Sunumu-4 • 25 y, kadın hasta • 1 hafta önce başlayan halsizlik, kol ve bacaklarda ekimoz • Her gün en az bir kere burun kanaması https: //www. profdrhisari. com
Olgu Sunumu-4 • FM’de – Genel durum düşkün – Konjonktiva ve yüz soluk görünümde – Dalak kot altında 4 cm palpable – KC kot altında 3 cm palpable – Servikal ve aksiller LAP https: //www. profdrhisari. com
Olgu Sunumu-4 • Yapılan tetkiklerde; – WBC: 88. 000 /µL – PNL: 5000 /µL – Lenfosit: 3000 /µL – Monosit: 80. 000 /µL – Hb: 7. 7 g/d. L – PLT: 32. 000 /µL – Sed: 104 mm/saat – CRP: 10 mg/d. L (<0. 5) https: //www. profdrhisari. com
Monositoz https: //www. profdrhisari. com
Olgu Sunumu-4 https: //www. profdrhisari. com
Bazofil – Bazofiller, kan lökositlerinin %0, 2'sini oluşturur. – Dokulardaki mast hücrelerine çok benzerler. – Koyu siyah granüller içerirler ve çekirdekleri net seçilemez – Granüllerinde heparin, histamin ve benzeri maddeleri, uygun bir uyarım sonucu hücre dışına boşaltırlar. – Anaflaktik tipteki allerjik olaylarda önemlidirler. https: //www. profdrhisari. com
Bazofili • Mutlak bazofil sayısının ~200/u. L'nin üzerinde olması • Bazofilik Lökositoz: Mutlak bazofil sayısının artışı ile birlikte lökosit sayısının 11. 000/u. L üzerinde olmasıdır. https: //www. profdrhisari. com
Bazofili • Tek başına nadirdir. • En sık görüldüğü ve belirgin olduğu hastalık KMLdir. • Daha az belirgin olmakla birlikte diğer kronik miyeloproliferatif hastalıklarda da sık görülür. • Bazofili nadiren ürtiker, peptik ülser, miksödem veya hiperhistaminemi ile birlikte bulunabilir. https: //www. profdrhisari. com
SÖZ SİZDE AKLIMIZDA NELER KALDI? https: //www. profdrhisari. com
SUNUMDAN ÇIKARIMLAR-1 • Lökositoz mutlaka irdelenmesi gereken bir laboratuvar bulgusudur. • Malignite dışındaki sebepler daha fazladır. • Tüm hastalarda infeksiyon ve inflamasyon öncelikli olarak düşünülmeli, fakat infeksiyon ve inflamasyon odağı ve akut faz reaktanları açısından hasta değerlendirilmelidir. https: //www. profdrhisari. com
SUNUMDAN ÇIKARIMLAR-2 • Lökositozlu hastada anemi ve trombositopeni malignite için alarm semptomudur. – Nötrofilik lökositoz sebebi infeksiyon ise anemi ve trombositopeni olabilir. https: //www. profdrhisari. com
SUNUMDAN ÇIKARIMLAR-3 • Nötrofilik lökositoz uzun süredir devam ediyor ve akut faz reaktanları düşük ise; – – Sigara içimi Gebelik İlaçlar Stres, egzersiz öncelikli olarak dışlanmalı • Fakat, MPH ve özellikle KML sessiz dönemi açısından uyanık olunmalıdır. • Splenomegali en önemli FM bulgusudur. https: //www. profdrhisari. com
SUNUMDAN ÇIKARIMLAR-4 • Çocuk ve genç hastalarda lenfositoz ve monositoz genelde viral infeksiyon lehinedir. • İleri yaş hastalarda akut ve kronik lösemilere DİKKAT! • İleri yaşda lenfositozla gelen, rastlantısal olarak saptanan veya uzun süreli öykü veren hastalarda KLL öncelikli olarak düşünülmelidir. https: //www. profdrhisari. com
SUNUMDAN ÇIKARIMLAR-5 • Eozinofili ve bazofili genelde malignite dışı nedenlere bağlıdır. • Akut faz reaktanlarının düşük olduğu ve uzun süredir devam eden olgularda MPH mutlaka akılda tutulmalı, dalak büyüklüğü değerlendirilmelidir. • Eozinofilik hastalarda malignite dışı neden bulunamadığı durumlarda lenfoproliferatif hastalıklar açısından uyanık olunmalıdır. https: //www. profdrhisari. com
SABRINIZ İÇİN TEŞEKKÜRLER https: //www. profdrhisari. com